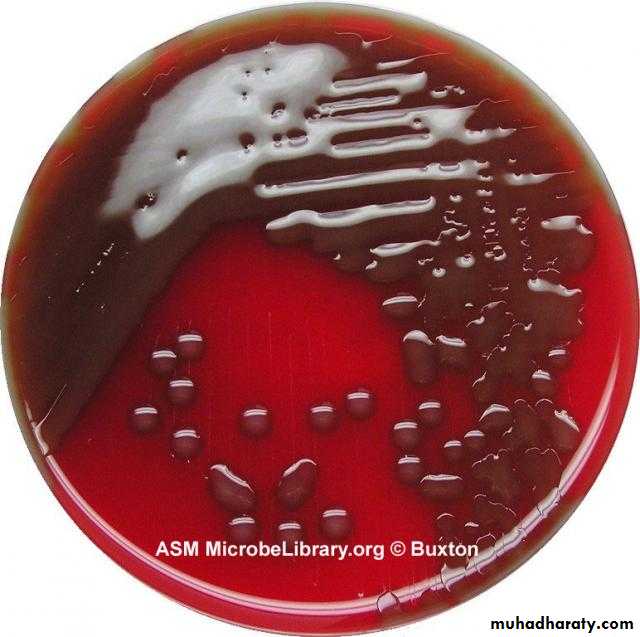
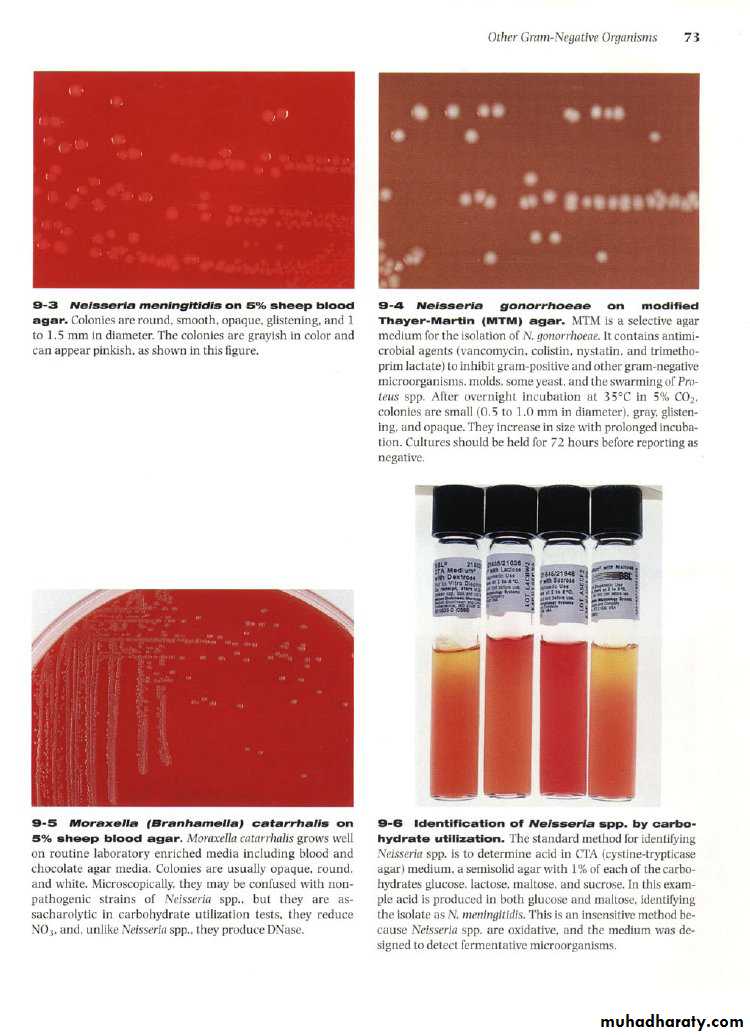

Streptococcus pneumoniapneumococcus
This bacterium G +ve ,diplococci gived alpha hemolytic on blood agar, which caused lobar pneumonia but it may also cause otitis media, sinusitis , meningitis and endocarditisPneumonia due to Str.pneumonia
Streptococcus pneumonia
Pneumococci
Streptococcus pneumonia, mucoid colonies
Way of infection
By the dropletClinical picture of lobar pneumonia:
1- sudden onset of fever.
2- sharp pleural pain.
3- sputum is exudative and rusty.
4- in untreated cases consolidation of the lung will occur.
Virulence factor
The virulence of the organism is a function of its capsule which prevent or delays ingestion of pneumococcus by phagocytes,Predisposing factor of pneumococcus
1- Viral and other respiratory infection that damage surface cells.2- Alcohol drinking.
3- Pulmonary congestion
4- Malnutrition
5- Heavy smoking
Antigenic structure
1- Peptidoglycan
2- Teichoic acid
3- Polysaccharide capsule, so the pneumococcus can be serologically classified into more than 90 types
4- M-protein
Diagnosis
Blood is drawn for culture and sputum is collected for demonstration of pneumococci by smear and culture.The sputum is examined by:
1- direct smear stained by gram stain, show G+ve diplococci lancet –shaped, there is unstained halo around the organism which represent its capsule
Diagnosis
2- Culture on blood agar: the colonies r alpha haemolytic and similar to Strep. Viridinas3- Biochemical reaction its bile solubility , sensitive to optochin, and ferement inulin to produce acid only.
4- Intraperitoneal injection of the sputum into white mouse , will lead to severe fatal septicaemia in the inoculated animal, and pneumococcus can be isolated and demonstrated in blood smear.
Right (optochin +) left (optochin negative)
Diagnosis
5- Serological typing: fresh emulsified sputum mixed with antiserum gives capsule swelling this reaction called quellung reaction.Treatment
Pneumococcus is sensitive to many antimicrobial drugs, early treatment usually results in rapid recovery.Penicillin G is the drug of choice, other beta lactam drugs like cephalosporin generations
Also pnumococcus susceptible to vancomycin.
Neisseria
The genus Neisseria includes large number of Gram-negative cocci . many of these are commensals in the respiratory tract which is called N. pharyngis . In this genus , there are two pathogenic members called : N. gonorrhoeae ( gonococcus ) & N. meningitides ( meningococcus ) .Neisseria gram stain
Neisseria gonorrhoeae
This species can cause 2 types of infections include :-A – Venereal infection : gonorrhoea which is transmitted by sexual contact .
B - Non-venereal infection : Ophthalmia neonatorum is transmitted by contamination of infant's eye during labour through the birth canal of a gonorrhoeal mother and vulvo-vaginitis in small girls through contaminated toilet seats & contaminated towels .
Gram stain of N.gonno
Antigenic structures of Neisseria:
1-Outer membrane protein (omp): which antigenic and antiphagostic factor2-Lipopolysaccharide which act as endotoxine
3-Pili which help neisseria to attach with epithelial host cells
Clinical manifestations
In the male , there is cause urithritis with yellow creamy pus & painful urination , the process may extend to prostate & epididymis .In female the infection may extend to the cervix to cause mucopurulent discharge , it may be then progress to the fallopian tube causing pelvic inflammation , fibrosis & obliteration of tubes with consequent sterility , chronic gonorrhoea is often asymptomatic .
Salpinitis
Diagnosis of gonorrhoea :-
Acute gonorrhoea can be detect by :a – Microscopical examination : direct smear from the discharge stained with Gram's stain to show the kidney shape G-ve diplococci present intracellular & extracellularily , non-spore forming .
b – Culture : this perform on blood agar or chocolate agar or Thayer-Martin medium incubated in 5% CO2 . the colonies are non haemolytic , non-pigmented or gray in color , smooth , circular , small & convex .
While in case of chronic gonorrhoea , in male , the morning drop of discharge or prostatic secretion after massage can be examined as before . In female , cervical swab may give positive results .
c – Serology : in this tests can be use serum & genital fluid that contain IgG and IgA antibodies against gonococcal pili , outer membrane proteins and lipopolysaccharide .
Treatment :-
Gonococci is treat by penicillin , but sensitivity test is indicated because gonococcal resistance to pencillin has gradually increased, therefore used new drugs like Ciprax single dose, .Neisseria meningitidis
This bacterium mainly cause cerebrospinal meningitis but it also can cause pharyngitis , adrenal haemorrhages & rarely myocarditis , the infection transmitted from the patient or carrier by droplets of nasopharyngeal secretions .N.meningitidis
Clinical manifestation of cerebrospinal meningitis :
This infection causes sudden onest of fever , vomiting , stiff neck , haemorrhage , skin rash and coma within a few hours .Diagnosis :
1 – C.S.F. examination :Lumber puncture is done under complet aseptic conditions , the CSF appear turbid ( it's clear colourless in normal case ) .
a – Direct smear : stained by Gram's stain , the bacteria appear as G-ve diplococci mainly intracellularly usually coffee bean in shape , non-spore forming .
b – Culture : this bacteria no growth in ordinary media , but grow on blood & chocolate agar in the presence of 5% CO2 , the colonies on blood agar are non-haemolytic , moist , devated , smooth , translucent , round & convex . Thayer-Martin medium containing antibiotic can also be used .
2 – Blood culture is perform in case of septicemia .
3 – Nasopharyngeal swab for culture is perform .4 – Biochemical reaction tests : this include fermentation of glucose & maltose with acid only . catalase & oxidase tests are positive
5– Serological test : Antigenically , meningococci are divided into several groups are A,B,C,w- 135&y , group A found in a most countries , while group c and w-135 associated with the epidemiology . specific anti-meningococcal antibiody in serum to detect colony by agglutination test , meningococcal antigen can be detect in C.S.F. of patient with active disease .